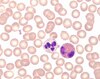

167206 SupelcoBottle adapter (PTFE), S40 (bottle thread) to GL45 (outer thread)
Recommended Products
Overview
| Replacement Information |
|---|
Pricing & Availability
| Catalogue Number | Availability | Packaging | Qty/Pack | Price | Quantity | |
|---|---|---|---|---|---|---|
| 1672060001 |
|
Plastic bag | 1 unit |
|
— |
| References |
|---|
| Product Information | |
|---|---|
| HS Code | 3926 90 97 |
| Applications |
|---|
| Biological Information |
|---|
| Physicochemical Information |
|---|
| Dimensions |
|---|
| Materials Information |
|---|
| Toxicological Information |
|---|
| Safety Information according to GHS | |
|---|---|
| Storage class | 10 - 13 Other liquids and solids |
| Safety Information |
|---|
| Product Usage Statements |
|---|
| Storage and Shipping Information | |
|---|---|
| Storage | NoTempLimit |
| Packaging Information |
|---|
| Transport Information |
|---|
| Supplemental Information |
|---|
| Specifications |
|---|
| Global Trade Item Number | |
|---|---|
| Catalogue Number | GTIN |
| 1672060001 | 04054839491115 |